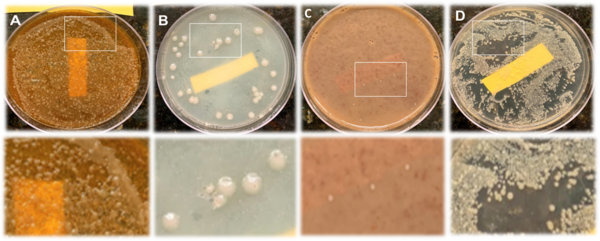
Antibacterial properties of household spices and toothpaste against oral bacteria

Almost all urban areas face the challenge of urban heat islands, areas with substantially hotter land surface temperatures than the surrounding rural areas. These areas are associated with worse air and water
quality, increased power outages, and increased heat-related illnesses. To learn more about these areas, Ustin et al. analyze satellite images of Cleveland neighborhoods to find out if there is a correlation between surface area development and surface temperature.